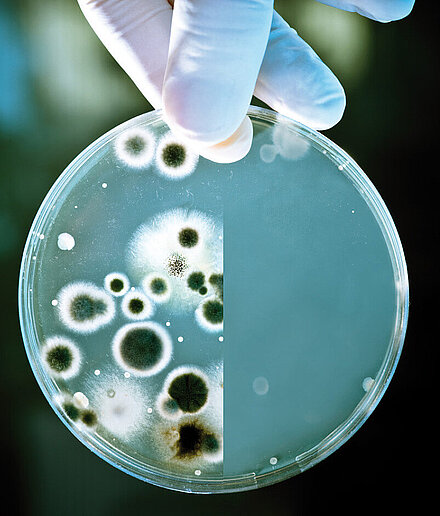

Pflegeserie


SoftCleaner
Das wasserbasierte Pflegemittel SoftCleaner mit Bestandteilen der SpriClean®-Beschichtung frischt veredelte Glasflächen auf, schützt und pflegt dabei langanhaltend. So bleibt der Abperleffekt der Veredlung erhalten. Die besondere Formel sorgt dabei für ein streifenfreies und brillantes Ergebnis. Vorsicht! Der SoftCleaner ist nicht für säureempfindliche Oberflächen wie Naturstein oder Marmor geeignet.
Pflegeset SoftClean-Plus
Das Pflegeset SoftClean-Plus „repariert“ in zwei einfachen Schritten. Es dient sowohl als Grundauffrischung bei einer Beschädigung als auch eine nachträgliche Veredelung mit SpriClean®. Die Glasoberfläche wird dabei verschlossen, Glaskorrosion verhindert und für Glanz und beste Pflegeeigenschaften gesorgt.
Kontaktieren Sie uns jetzt, um die spezielle Pflegeserie zu kaufen.